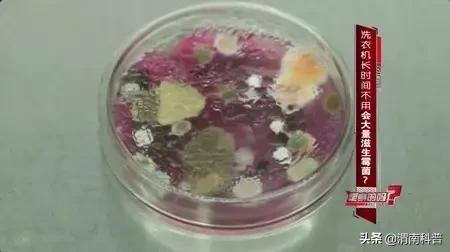
科普天天洗澡竟有两大危害,天天洗衣服衣服怎么还会脏

日常生活中
洗衣机绝对是一大得力帮手
把脏衣物放进去启动后就不用再管
到时间取出晾晒就行了
操作简单又快捷

洗衣机被誉为历史上100个最伟大的发明之一,它的伟大之处,不仅是代表着现代工业革命的智慧成果,更是为大家的日常生活创造了很大便利。
但这种方便的背后也潜藏着隐患,比如说:很多小伙伴会忽略对洗衣机的清理。

洗衣机的滚筒、洗衣槽等地方很容易藏污纳垢,若不定期清理,这些污垢会附着在衣物上,对衣物造成二次污染,今天我们来研究一下:
洗衣机的工作原理是什么?
怎样清理洗衣机?
使用洗衣机的时候要注意哪些方面?


洗衣机

在大海中航行时,水手们会把脏衣物塞进一个布包中,用绳子一端系在船上,布包则扔进大海中。
航行途中利用海水持续地搅动、拍打,衣服就能洗得干干净净。
受到“大海洗衣”方式的启发,1858年,美国人汉密尔顿·史密斯发明了首台洗衣机,1911年,世界上第一台电动洗衣机诞生了。

洗衣机的洗涤过程主要是利用机械产生的排渗、冲刷等机械作用以及洗涤剂的润湿、分散作用,将污垢拉入水中从而实现洗净的目的。
洗衣机在洗涤衣物时,是通过衣物和洗涤液在洗衣机桶内不断翻滚、摩擦、搅动达到洗涤衣物的功能。

洗衣机的甩干功能是应用了物理学中的离心力原理,洗衣机在甩干衣物时,电动机带动桶高速旋转。
利用离心力原理将衣物中的水从桶壁的小孔甩出去从而使水与衣物分离达到甩干衣物的目的。


衣物二次污染

上海市疾控中心曾抽样检查了128台使用半年以上的洗衣机,结果显示:
洗衣机洗涤桶内槽中的霉菌检出率为60.2%,细菌总数检出率为81.3%,总大肠菌群检出率高达100%,有54.7%的洗衣机同时含有以上三种菌类。

央视“是真的吗”栏目曾经做过一次调查,检测技术人员对一周未使用、两周未使用、两个月未使用的洗衣机进行实验。
工作人员对洗衣水进行采样发现:一周未使用的洗衣机里面每毫升有5个菌落,两周未用的洗衣机里面每毫升有6个菌落,两个月未使用的洗衣机里面菌落数多不可计。
图源生命时报
火箭军总医院皮肤科主任医师杨维玲说:
霉菌会引发一些皮肤疾病,如果把内衣*裤内**都放在洗衣机里面洗,可能也会传染上霉菌性疾病。像霉菌性阴道炎、*头龟**炎、皮肤过敏性疾病,如慢性*麻疹荨**等。

图源生命时报
而且霉菌对孩子的影响远高于成人,霉菌感染一般跟免疫功能有关,免疫功能强的人可能受感染机会小。
孩子的免疫功能相对较弱,所以受感染的几率比较大。

相关研究指出,洗衣机使用越久,洗衣次数越频繁,洗衣槽里的霉菌孢子数量就越多,进而附着于衣物上造成二次污染。
所以为避免洗衣机成为疾病感染源,一定要定期清理洗衣机。
如果刚清洗完毕的衣服上面就有棉絮、小黑渍,甚至发出异味,就意味着你的洗衣机该清洗了。


如何清理洗衣机

日常生活中我们可以自己做简单的清洁,具体操作方法是:洗衣槽放满水,或利用洗衣机的“筒清洁”功能,加入1杯(约100至120克)小苏打粉。
让洗衣机搅动3至5分钟后,静置浸泡30分钟至1小时后把水放掉,然后再以一般清洗程序清洗一次。
小苏打成分是弱碱性的碳酸氢钠,有清洁、除臭效果,还能软化水质,避免形成皂垢,污染洗衣槽。

洗衣机清洁干净后,放满水,加入1小瓶白醋(约300毫升),或1杯柠檬酸,让洗衣机搅动几分钟之后,浸泡30分钟以上,再以清水清洗一次即可。
白醋或柠檬酸有天然杀菌功能,建议到药店买由天然植物成分制成的柠檬酸。

也可以选择厂商指定的除垢剂或者清洁剂,更加安全和省心。
清洁剂的主要作用在于通过化学成分溶解洗衣机内胆、夹层等部位的顽垢,同时去除洗衣机内部异味。
将清洗剂倒入洗衣机,启动洗涤程序后静置2-6小时,具体的用量一般在清洗剂上都会有说明。
使用清洗剂后,桶壁上可能会有残留,这属于正常现象,用毛巾擦干桶壁即可。

对于多年没清洗过的洗衣机,会有部分强力粘附在桶壁及沟壑里的污垢,清洗剂的清除效果就比较有限了,最好是找专业的清洗师傅进行拆机清洗。
由于洗衣机的内部结构比较复杂,小伙伴们不要贸然拆开进行清洁,不然不但清洗不干净,反而会损坏内部零件。
专业人员会对洗衣机进行专业拆解,并且会配备专业强效的清洁剂,在不损伤内筒的同时有效去污,同时对内部零件进行保养。


使用洗衣机的注意事项

1、洗完后30分钟后再盖
很多小伙伴用完洗衣机后,会随手盖上洗衣机的盖子,有的人还喜欢套上洗衣罩,这其实是不正确的。
洗衣机盖上盖子不利于水汽蒸发,用完后盖子总是关着,在潮湿的环境下会滋生大量细菌。

而且洗衣罩的遮挡更是给细菌提供了良好的生存环境,这也是有些人用洗衣机洗完衣服穿在身上会痒的原因,皮肤比较敏感的还可能会导致皮肤过敏。
建议洗完衣服后打开盖子通风30分钟至1小时,等水汽散去桶内干燥后再盖上盖子。

2、消毒液和洗涤剂避免同时用
有的小伙伴会把消毒液与洗涤剂一起使用,认为可以起到消毒杀菌的作用,其实这种做法是不正确的。
消毒液中的成分会跟洗涤剂相互作用,对皮肤有害。正确的方法应该是,先用消毒液浸泡待洗衣物,漂洗过后,再用洗涤剂按照正常步骤洗涤。

3、清洁过滤网
洗衣机过滤槽网内易积攒大量水垢、毛屑等脏渍以及洗衣液的残留物,每次洗完衣服后,最好清理一下过滤网,太脏的话用小刷子刷洗干净,晾干后放进去。

4、分开洗,洗完及时取出
床上用品等与其他衣服分开洗,袜子、内衣裤应尽量手洗。
洗完衣物后,应该立刻将衣服拿出来晒干,尽量不要留在洗衣机内闷干,因为这样的环境很容易滋生细菌。

( 原创 小科 陕西科普 )